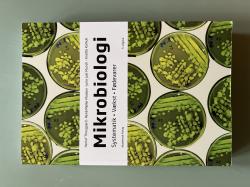
Billede af bogen Mikrobiologi - Systematik, vækst, fødevarer Billede af bogen Mikrobiologi - Systematik, vækst, fødevarer

Senest opdateret 4. november
5. udgave fra 2018 på Akademisk Forlag
Oplag: 3.
ISBN: 978-87-500-5920-2
Kategori: Biologi
pris: 470 kr – stand: ★★★★★
Vægt: 1490 gram
Mikrobiologi bog, en del af bogpakken til laborantuddannelsen på Københavns Professionshøjskole.
Find flere bøger fra samme bogsælger og spar penge i fragt!. Klik her og find flere bøger fra samme bogsælger